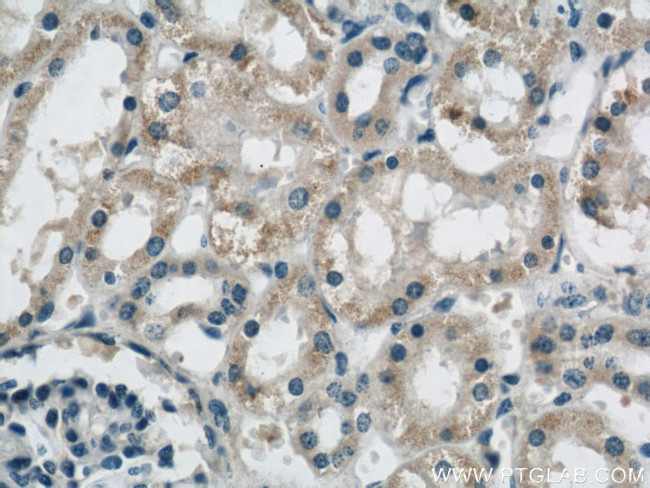
B3GALNT1 Antibody in Immunohistochemistry (Paraffin) (IHC (P))

Search
Proteintech
B3GALNT1 Polyclonal Antibody
{{$productOrderCtrl.translations['antibody.pdp.commerceCard.promotion.promotions']}}
{{$productOrderCtrl.translations['antibody.pdp.commerceCard.promotion.viewpromo']}}
{{$productOrderCtrl.translations['antibody.pdp.commerceCard.promotion.promocode']}}: {{promo.promoCode}} {{promo.promoTitle}} {{promo.promoDescription}}. {{$productOrderCtrl.translations['antibody.pdp.commerceCard.promotion.learnmore']}}
产品信息
22048-1-AP
种属反应
宿主/亚型
分类
类型
抗原
偶联物
形式
浓度
规格
纯化类型
保存液
内含物
保存条件
运输条件
产品详细信息
Immunogen sequence: VIERVNWMY FYEYEPIYRQ DFHFTLREHS NCSHQNPFLV ILVTSHPSDV KARQAIRVTW GEKKSWWGYE VLTFFLLGQE AEKEDKMLAL SLEDEHLLYG DIIRQDFLDT YNNLTLKTIM AFRWVTEFCP NAKYVMKTDT DVFINTGNLV KYLLNLNHSE KFFTGYPLID NYSYRGFYQK THISYQEYPF KVFPPYCSGL GYIMSRDLVP RIYEMMGHVK PIKFEDVYVG ICLNLLKVNI HIPEDTNLFF LYRIHLDVCQ LRRVIAAHGF SSKEIITFWQ VMLRNTTCHY (43-331 aa encoded by BC047618)
靶标信息
B3GALNT1 gene ontology annotations related to this gene include protein glycosylation.
仅用于科研。不用于诊断过程。未经明确授权不得转售。
篇参考文献 (0)
生物信息学
蛋白别名: b3Gal-T3; B3GALT3; Beta-1,3-galactosyltransferase 3; Beta-1,3-GalNAc-T1; Beta-1,3-GalTase 3; beta-3-GalNAc-T1; Beta-3-Gx-T3; beta3Gal-T3; beta3GalT3; Brainiac 1; brainiac1; Galactosylgalactosylglucosylceramide beta-D-acetyl-galactosaminyltransferase; Globoside blood group; Globoside synthase; globotriaosylceramide 3-beta-N-acetylgalactosaminyltransferase; Mbrn 1; OR2; P antigen synthase; P blood group globoside; UDP-Gal:betaGlcNAc beta 1,3-galactosyltransferase III; UDP-Gal:betaGlcNAc beta 1,3-galactosyltransferase, polypeptide 3; UDP-Gal:betaGlcNAc beta 1,3-galactosyltransferase, polypeptide 3 (Globoside blood group); UDP-GalNAc:beta-1,3-N-acetylgalactosaminyltransferase 1; UDP-GalNAc:betaGlcNAc beta 1,3-galactosaminyltransferase, polypeptide 1; UDP-GalNAc:betaGlcNAc beta-1,3-galactosaminyltransferase, polypeptide 1 (Globoside blood group); UDP-N-acetylgalactosamine:globotriaosylceramide beta-1,3-N-acetylgalactosaminyltransferase; unnamed protein product
基因别名: 3-GalNAc-T1; 3-GalTase; b3Gal-T3; B3GALANT1; B3GALNT1; B3GALT3; B3gt3; beta-1; beta-3-Gx-T3; beta3Gal-T3; galT3; Gb4Cer; GLCT3; GLOB; Mbrn1; P1; UNQ531/PRO1074
UniProt ID: (Human) O75752, (Mouse) Q920V1, (Rat) Q6AY39
Entrez Gene ID: (Human) 8706, (Mouse) 26879, (Rat) 310508